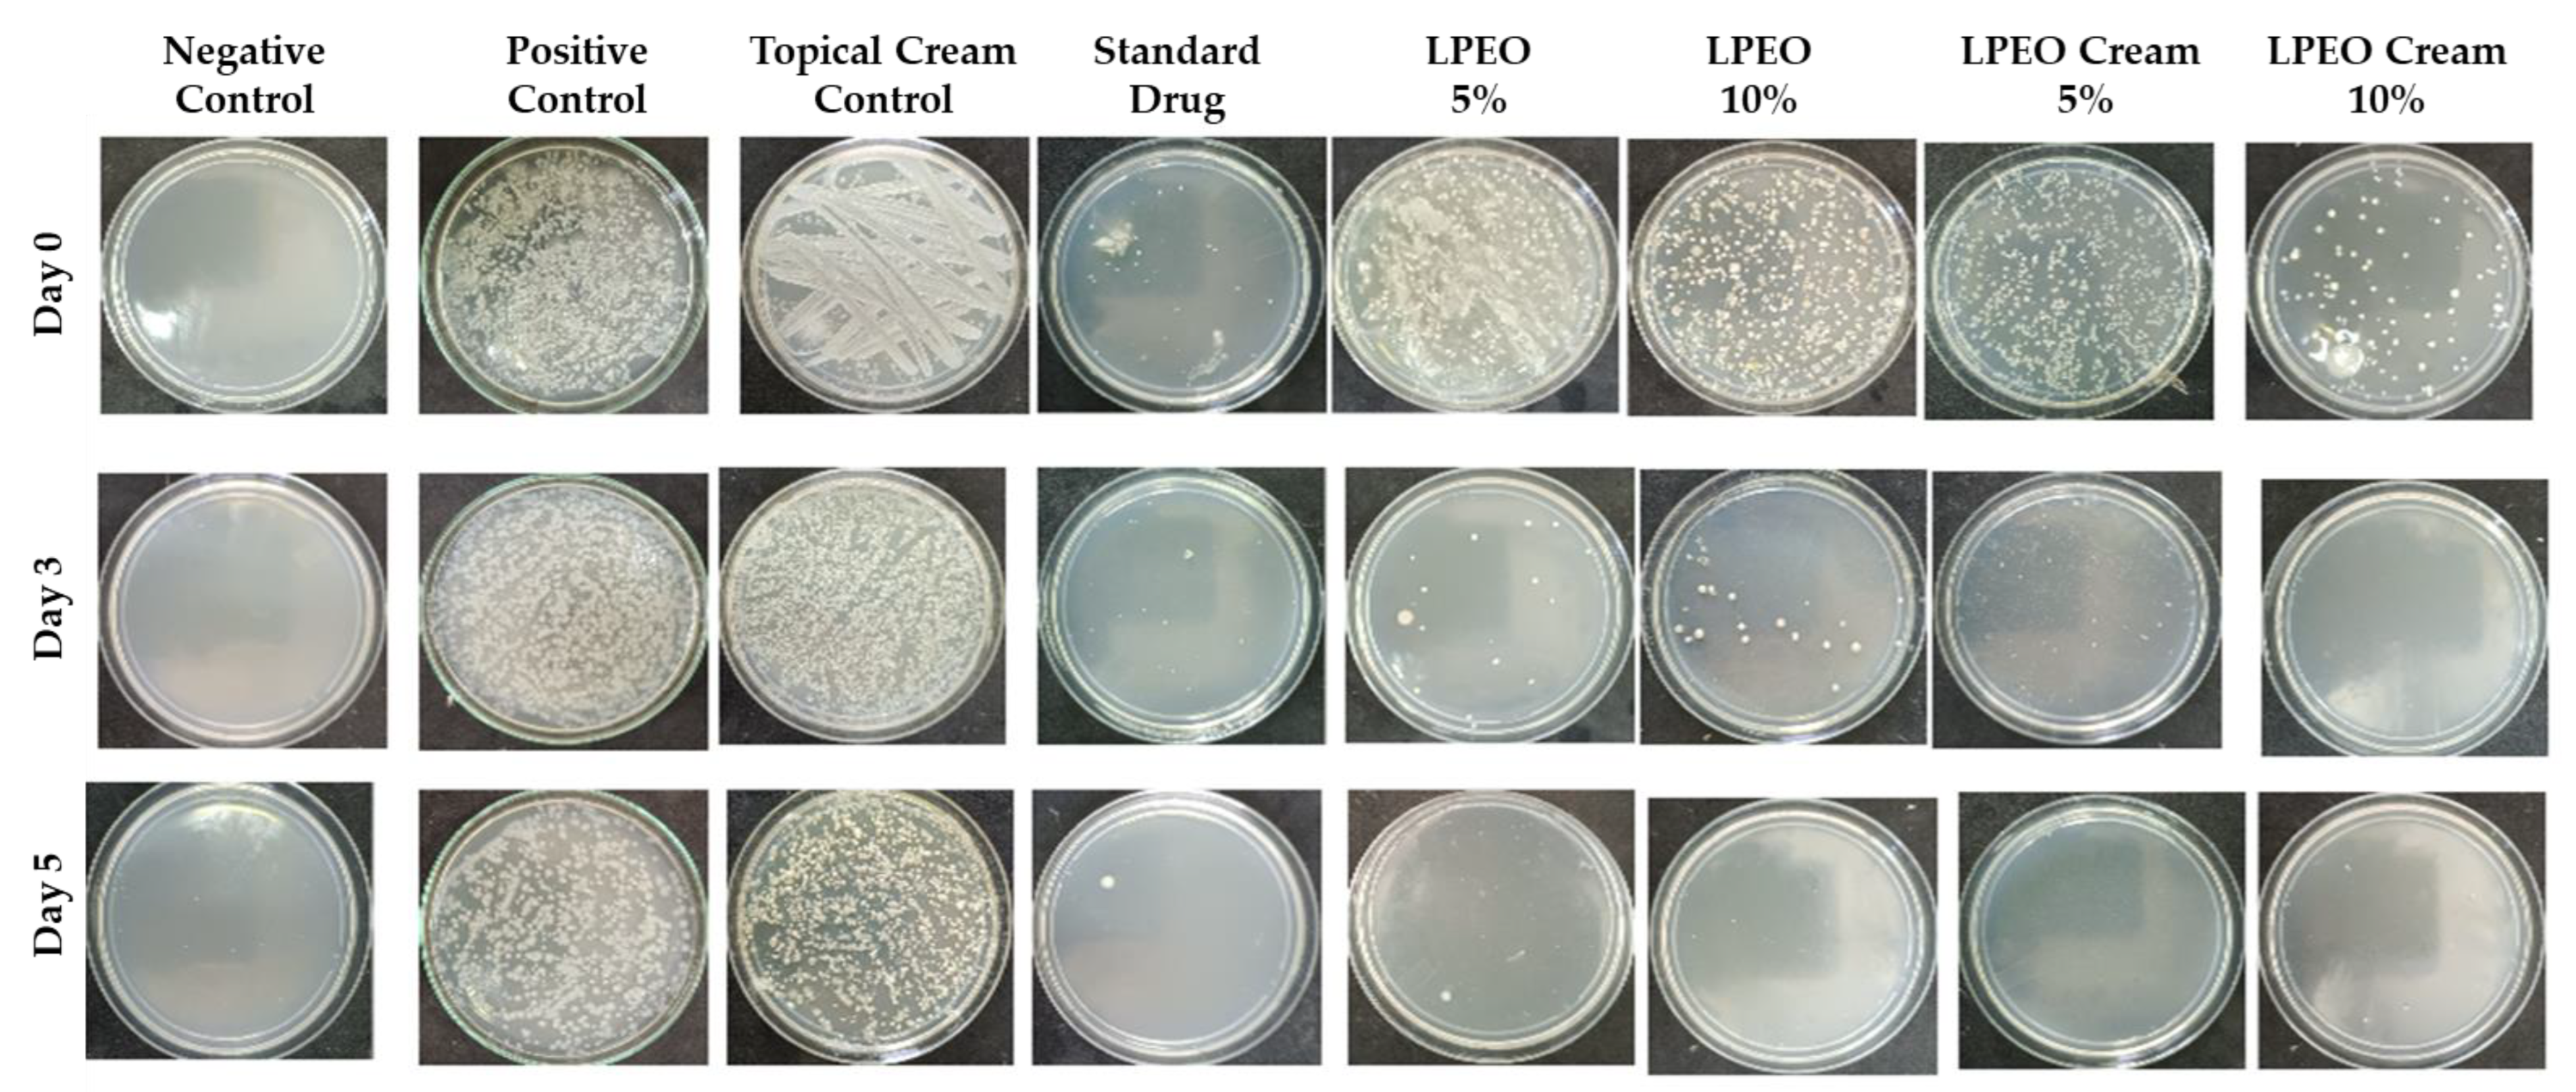

Bioactive Potential of Chitosan–Oleic Acid Nanoparticles Loaded with Lemon Peel Essential Oil for Topical Treatment of Vulvovaginal Candidiasis
Abstract
1. Introduction
2. Results and Discussion
2.1. Characterization of the Developed LPEO-Loaded CH-OA-NPs
2.1.1. LPEO Encapsulation Efficiency
2.1.2. Particle Size, Polydispersity Index (PDI), and Zeta Potential Assessments
2.1.3. Fourier Transform Infrared Spectroscopy (FT-IR) Analysis
2.1.4. Transmission Electron Microscopy (TEM) Analysis
2.1.5. In Vitro Antimicrobial Activity Assessment of LPEO and LPEO-CH-OA-NPs
2.2. Characterization of the Formulated LPEO-CH-OA-NP Topical Cream
2.2.1. Rheology Assessment
2.2.2. In Vitro Release Profile
2.2.3. LPEO-Derived Compounds: Tentative Identification by LC-ESI-QqTOF-HRMS
2.2.4. In Silico Antifungal Activity of the Identified LPEO-Derived Compounds
2.3. In Vivo Properties Assessment of the LPEO and LPEO-CH-OA-NPs Topical Cream
2.3.1. Acute Toxicity Evaluation: Hematological and Biochemical Analysis
Effect on Leukocytes and Differential Leukocytic Count
Effect on Platelets
Hematological Parameters Assessment
Oxidative Stress Assessment
Effect on Inflammatory Markers
2.3.2. Antimicrobial Evaluation
2.3.3. Histopathological Assessments
3. Materials and Methods
3.1. Materials
3.2. Extraction of Lemon Peel Essential Oil (LPEO)
3.3. Development of LPEO-Loaded Chitosan–Oleic Acid Nanoparticles (CH-OA-NPs)
3.4. Characterization of the Developed LPEO-CH-OA-NPs
3.4.1. LPEO Encapsulation Efficiency
3.4.2. Particle Size, Polydispersity Index (PDI), and Zeta Potential Assessments
3.4.3. Fourier Transform Infrared Spectroscopy (FT-IR) Analysis
3.4.4. Transmission Electron Microscopy (TEM) Analysis
3.5. In Vitro Antimicrobial Activity Assessment of LPEO and LPEO-CH-OA-NPs
3.6. Formulation and Characterization of the LPEO-CH-OA-NPs Topical Cream
3.6.1. Formulation of the LPEO-CH-OA-NPs Topical Cream
3.6.2. Rheology Assessment of the LPEO-CH-OA-NP Topical Cream
3.6.3. In Vitro Release Profile of the LPEO-CH-OA-NPs
3.6.4. LPEO-Derived Compounds Analysis by LC-ESI-QqTOF-HRMS
Compound Extraction from the Topical Cream Formulation
Compounds Tentative Identification by LC-ESI-QqTOF-HRMS
3.6.5. In Silico Antifungal Activity of LPEO-Derived Compounds
3.7. In Vivo Assays on Mice and Rats
3.7.1. Acute Toxicity Assay on Mice
3.7.2. Vaginal Infection Model and Experimental Design on Rats
Animal Model
Surgical Procedure and Infection Induction
Experimental Groups
Antimicrobial Assessment of Free LPEO and LPEO-CH-OA-NPs Cream After Vaginal Infection Induction
Hematological and Biochemical Analysis
Histopathological Analysis
3.8. Statistical Analysis
4. Conclusions
Author Contributions
Funding
Institutional Review Board Statement
Informed Consent Statement
Data Availability Statement
Acknowledgments
Conflicts of Interest
References
- Balakrishnan, S.N.; Yamang, H.; Lorenz, M.C.; Chew, S.Y.; Than, L.T.L. Role of vaginal mucosa, host immunity and microbiota in vulvovaginal candidiasis. Pathogens 2022, 11, 618. [Google Scholar] [CrossRef] [PubMed]
- Falahati, M.; Akhlaghi, L.; Abianeh, M.; Assadi, M.; Nami, S.; Fateh, R. Prevalence of Candida albicans and Trichomonas vaginalis Infections in women. Life Sci. J. 2013, 10, 479–483. [Google Scholar]
- Bona, E.; Cantamessa, S.; Pavan, M.; Novello, G.; Massa, N.; Rocchetti, A.; Berta, G.; Gamalero, E. Sensitivity of Candida albicans to essential oils: Are they an alternative to antifungal agents? J. Appl. Microbiol. 2016, 121, 1530–1545. [Google Scholar] [CrossRef]
- Shirsat, S.P.; Tambe, K.P.; Dhakad, G.G.; Patil, P.A.; Jain, R.S. Review on antifungal agents. Res. J. Pharmacol. Pharmacodyn. 2021, 13, 147–154. [Google Scholar] [CrossRef]
- El-Garhy, O.H. An overview of the azoles of interest. Int. J. Curr. Pharm. Res. 2015, 7, 1–6. [Google Scholar]
- Saracino, I.M.; Foschi, C.; Pavoni, M.; Spigarelli, R.; Valerii, M.C.; Spisni, E. Antifungal activity of natural compounds vs. candida spp.: A mixture of cinnamaldehyde and eugenol shows promising in vitro results. Antibiotics 2022, 11, 73. [Google Scholar] [CrossRef] [PubMed]
- Hammoudi, N.; Ziani Cherif, H.; Borsali, F.; Benmansour, K.; Meghezzi, A. Preparation of active antimicrobial and antifungal alginate-montmorillonite/lemon essential oil nanocomposite films. Mater. Technol. 2020, 35, 383–394. [Google Scholar] [CrossRef]
- Li, Z.-H.; Cai, M.; Liu, Y.-S.; Sun, P.-L.; Luo, S.-L. Antibacterial activity and mechanisms of essential oil from Citrus medica L. var. sarcodactylis. Molecules 2019, 24, 1577. [Google Scholar] [CrossRef]
- Amaral, A.C.; Saavedra, P.H.; Souza, A.C.O.; de Melo, M.T.; Tedesco, A.C.; Morais, P.C.; Felipe, M.S.S.; Bocca, A.L. Miconazole loaded chitosan-based nanoparticles for local treatment of vulvovaginal candidiasis fungal infections. Colloids Surf. B Biointerfaces 2019, 174, 409–415. [Google Scholar] [CrossRef]
- Kalidason, A.; Kuroiwa, T. Nanoencapsulation of α-mangostin using chitosan-oleic acid complexes: Evaluation of storage stability, in vitro release properties in simulated digestive environment, and bioaccessibility. LWT 2023, 188, 115406. [Google Scholar] [CrossRef]
- Shalaby, E.S.; Aboutaleb, S.; Ismail, S.A.; Yassen, N.N.; Sedik, A.A. Chitosan tamarind-based nanoparticles as a promising approach for topical application of curcumin intended for burn healing: In vitro and in vivo study. J. Drug Target. 2023, 31, 1081–1097. [Google Scholar] [CrossRef] [PubMed]
- Khalid, A.; Ahmed, N.; Qindeel, M.; Asad, M.I.; Khan, G.M.; Ur Rehman, A. Development of novel biopolymer-based nanoparticles loaded cream for potential treatment of topical fungal infections. Drug Dev. Ind. Pharm. 2021, 47, 1090–1099. [Google Scholar] [CrossRef] [PubMed]
- Tügen, A.; Ocak, B.; Özdestan-Ocak, Ö. Development of gelatin/chitosan film incorporated with lemon essential oil with antioxidant properties. J. Food Meas. Charact. 2020, 14, 3010–3019. [Google Scholar] [CrossRef]
- Wang, X.; Sun, Y.; Liu, Z.; Huang, X.; Yi, F.; Hou, F.; Zhang, F. Preparation and characterization of chitosan/zein film loaded with lemon essential oil: Effects on postharvest quality of mushroom (Agaricus bisporus). Int. J. Biol. Macromol. 2021, 192, 635–643. [Google Scholar] [CrossRef]
- Jiang, T.; Wang, C.; Liu, W.; Li, Y.; Luan, Y.; Liu, P. Optimization and characterization of lemon essential oil entrapped from chitosan/cellulose nanocrystals microcapsules. J. Appl. Polym. Sci. 2021, 138, 51265. [Google Scholar] [CrossRef]
- Narkar, M.; Sher, P.; Pawar, A. Stomach-Specific Controlled Release Gellan Beads of Acid-Soluble Drug Prepared by Ionotropic Gelation Method. AAPS PharmSciTech 2010, 11, 267–277. [Google Scholar] [CrossRef]
- Gooneh-Farahani, S.; Naghib, S.M.; Naimi-Jamal, M.R. A Novel and Inexpensive Method Based on Modified Ionic Gelation for pH-responsive Controlled Drug Release of Homogeneously Distributed Chitosan Nanoparticles with a High Encapsulation Efficiency. Fibers Polym. 2020, 21, 1917–1926. [Google Scholar] [CrossRef]
- Koppolu, B.p.; Smith, S.G.; Ravindranathan, S.; Jayanthi, S.; Suresh Kumar, T.K.; Zaharoff, D.A. Controlling chitosan-based encapsulation for protein and vaccine delivery. Biomaterials 2014, 35, 4382–4389. [Google Scholar] [CrossRef]
- Omar Zaki, S.S.; Ibrahim, M.N.; Katas, H. Particle Size Affects Concentration-Dependent Cytotoxicity of Chitosan Nanoparticles towards Mouse Hematopoietic Stem Cells. J. Nanotechnol. 2015, 2015, 919658. [Google Scholar] [CrossRef]
- Şenyiğit, T.; Sonvico, F.; Barbieri, S.; Özer, Ö.; Santi, P.; Colombo, P. Lecithin/chitosan nanoparticles of clobetasol-17-propionate capable of accumulation in pig skin. J. Control. Release 2010, 142, 368–373. [Google Scholar] [CrossRef]
- Guo, J.; Ping, Q.; Jiang, G.; Huang, L.; Tong, Y. Chitosan-coated liposomes: Characterization and interaction with leuprolide. Int. J. Pharm. 2003, 260, 167–173. [Google Scholar] [CrossRef] [PubMed]
- Ibrahim, F.M.; Shalaby, E.S.; El-Liethy, M.A.; Abd-Elmaksoud, S.; Mohammed, R.S.; Shalaby, S.I.; Rodrigues, C.V.; Pintado, M.; Habbasha, E.S.E. Formulation and Characterization of Non-Toxic, Antimicrobial, and Alcohol-Free Hand Sanitizer Nanoemulgel Based on Lemon Peel Extract. Cosmetics 2024, 11, 59. [Google Scholar] [CrossRef]
- Manaila, E.; Berechet, M.D.; Stelescu, M.D.; Craciun, G.; Mihaiescu, D.E.; Purcareanu, B.; Calinescu, I.; Fudulu, A.; Radu, M. Comparation between chemical compositions of some essential oils obtained by hydrodistillation from citrus peels. Rev. Chim. 2016, 67, 107–112. [Google Scholar]
- Tripathy, N.; Ahmad, R.; Ko, H.A.; Khang, G.; Hahn, Y.-B. Enhanced anticancer potency using an acid-responsive ZnO-incorporated liposomal drug-delivery system. Nanoscale 2015, 7, 4088–4096. [Google Scholar] [CrossRef]
- Jiménez-Rojo, N.; Lete, M.G.; Rojas, E.; Gil, D.; Valle, M.; Alonso, A.; Moya, S.E.; Goñi, F.M. Lipidic nanovesicles stabilize suspensions of metal oxide nanoparticles. Chem. Phys. Lipids 2015, 191, 84–90. [Google Scholar] [CrossRef]
- Grigoriou, O.; Baka, S.; Makrakis, E.; Hassiakos, D.; Kapparos, G.; Kouskouni, E. Prevalence of clinical vaginal candidiasis in a university hospital and possible risk factors. Eur. J. Obstet. Gynecol. Reprod. Biol. 2006, 126, 121–125. [Google Scholar] [CrossRef] [PubMed]
- Gonçalves, B.; Ferreira, C.; Alves, C.T.; Henriques, M.; Azeredo, J.; Silva, S. Vulvovaginal candidiasis: Epidemiology, microbiology and risk factors. Crit. Rev. Microbiol. 2016, 42, 905–927. [Google Scholar] [CrossRef]
- Angane, M.; Swift, S.; Huang, K.; Butts, C.A.; Quek, S.Y. Essential oils and their major components: An updated review on antimicrobial activities, mechanism of action and their potential application in the food industry. Foods 2022, 11, 464. [Google Scholar] [CrossRef]
- Jing, L.; Lei, Z.; Li, L.; Xie, R.; Xi, W.; Guan, Y.; Sumner, L.W.; Zhou, Z. Antifungal activity of citrus essential oils. J. Agric. Food Chem. 2014, 62, 3011–3033. [Google Scholar] [CrossRef]
- Ben Hsouna, A.; Ben Halima, N.; Smaoui, S.; Hamdi, N. Citrus lemon essential oil: Chemical composition, antioxidant and antimicrobial activities with its preservative effect against Listeria monocytogenes inoculated in minced beef meat. Lipids Health Dis. 2017, 16, 146. [Google Scholar] [CrossRef]
- Ammar, H.O.; Ghorab, M.M.; Mostafa, D.M.; Abd El-Alim, S.H.; Kassem, A.A.; Salah, S.; Shalaby, E.S. Development of folic acid–loaded nanostructured lipid carriers for topical delivery: Preparation, characterisation and ex vivo investigation. J. Microencapsul. 2020, 37, 366–383. [Google Scholar] [CrossRef] [PubMed]
- Athamneh, N.; Tashtoush, B.; Qandil, A.; Al-Tanni, B.; Obaidat, A.; Al-Jbour, N.; Qinna, N.; Al-Sou’od, K.; Al-Remawi, M.; Badwan, A. A new controlled-release liquid delivery system based on diclofenac potassium and low molecular weight chitosan complex solubilized in polysorbates. Drug Dev. Ind. Pharm. 2013, 39, 1217–1229. [Google Scholar] [CrossRef] [PubMed]
- Khan, M.M.; Madni, A.; Tahir, N.; Parveen, F.; Khan, S.; Jan, N.; Ali, A.; Abdurrahim, M.; Farooq, U.; Khan, M.I. Co-delivery of curcumin and cisplatin to enhance cytotoxicity of cisplatin using lipid-chitosan hybrid nanoparticles. Int. J. Nanomed. 2020, 15, 2207–2217. [Google Scholar] [CrossRef]
- Anwer, M.K.; Iqbal, M.; Muharram, M.M.; Mohammad, M.; Ezzeldin, E.; Aldawsari, M.F.; Alalaiwe, A.; Imam, F. Development of lipomer nanoparticles for the enhancement of drug release, anti-microbial activity and bioavailability of delafloxacin. Pharmaceutics 2020, 12, 252. [Google Scholar] [CrossRef] [PubMed]
- Woo, J.; Misran, M.; Lee, P.; Tan, L. Development of a Controlled Release of Salicylic Acid Loaded Stearic Acid-Oleic Acid Nanoparticles in Cream for Topical Delivery. Sci. World J. 2014, 2014, 205703. [Google Scholar] [CrossRef]
- Farboud, E.S.; Nasrollahi, S.A.; Tabbakhi, Z. Novel formulation and evaluation of a Q10-loaded solid lipid nanoparticle cream: In vitro and in vivo studies. Int. J. Nanomed. 2011, 6, 611–617. [Google Scholar] [CrossRef]
- Ibrahim, F.M.; Mohammed, R.S.; Abdelsalam, E.; Ashour, W.E.; Magalhães, D.; Pintado, M.; El Habbasha, E.S. Egyptian Citrus Essential Oils Recovered from Lemon, Orange, and Mandarin Peels: Phytochemical and Biological Value. Horticulturae 2024, 10, 180. [Google Scholar] [CrossRef]
- da Nóbrega Alves, D.; Monteiro, A.F.M.; Andrade, P.N.; Lazarini, J.G.; Abílio, G.M.F.; Guerra, F.Q.S.; Scotti, M.T.; Scotti, L.; Rosalen, P.L.; Castro, R.D.d. Docking Prediction, Antifungal Activity, Anti-Biofilm Effects on Candida spp., and Toxicity against Human Cells of Cinnamaldehyde. Molecules 2020, 25, 5969. [Google Scholar] [CrossRef]
- Lv, Q.-Z.; Yan, L.; Jiang, Y.-Y. The synthesis, regulation, and functions of sterols in Candida albicans: Well-known but still lots to learn. Virulence 2016, 7, 649–659. [Google Scholar] [CrossRef]
- Vigbedor, B.Y.; Osei Akoto, C.; Neglo, D. Isolation and identification of flavanone derivative eriodictyol from the methanol extract of afzelia Africana bark and its antimicrobial and antioxidant activities. Evid.-Based Complement. Altern. Med. 2023, 2023, 9345047. [Google Scholar] [CrossRef]
- Abdu, K.M.; Erahioui, R.; Zahidi, A.; Khedid, K.; IBN AHMED, S. Evaluation of antifungal activity of lemon (Citrus lemon) in Marrakech and Kenitra cities Morocco. Egypt. J. Chem. 2021, 64, 4183–4190. [Google Scholar] [CrossRef]
- Geisler, W.; Yu, S.; Venglarik, M.; Schwebke, J. Vaginal leucocyte counts in women with bacterial vaginosis: Relation to vaginal and cervical infections. Sex. Transm. Infect. 2004, 80, 401–405. [Google Scholar] [CrossRef] [PubMed][Green Version]
- Qu, S.; Chen, L.; Tian, H.; Wang, Z.; Wang, F.; Wang, L.; Li, J.; Ji, H.; Xi, L.; Feng, Z. Effect of perillaldehyde on prophylaxis and treatment of vaginal candidiasis in a murine model. Front. Microbiol. 2019, 10, 1466. [Google Scholar] [CrossRef]
- Li, J.; Jin, Z.-H.; Li, J.-S.; Su, L.-Y.; Wang, Y.-X.; Zhang, Y.; Qin, D.-M.; Rao, G.-X.; Wang, R.-R. Activity of compound agrimony enteritis capsules against invasive candidiasis: Exploring the differences between traditional Chinese medicine prescriptions and its main components in the treatment of diseases. J. Ethnopharmacol. 2021, 277, 114201. [Google Scholar] [CrossRef] [PubMed]
- Talaei, Z.; Sheikhbahaei, S.; Ostadi, V.; Hakemi, M.G.; Meidani, M.; Naghshineh, E.; Yaran, M.; Naeini, A.E.; Sherkat, R. Recurrent vulvovaginal candidiasis: Could it be related to cell-mediated immunity defect in response to Candida antigen? Int. J. Fertil. Steril. 2017, 11, 134. [Google Scholar]
- Kustimur, S.; Kalkanci, A.; Akbulut, G.; Gonul, B.; Bulduk, E.; Aksakal, F.N.; Yetkin, I. The effect of vaginal candidiasis on the levels of the oxidative biomarkers in plasma and tissue samples of diabetic rats. Mycopathologia 2007, 164, 217–224. [Google Scholar] [CrossRef]
- Verma, A.K. Anti-oxidant activities of biopolymeric nanoparticles: Boon or bane. J. Pharm. Res. 2014, 8, 871–876. [Google Scholar]
- Lopes Campêlo, L.M.; Moura Gonçalves, F.C.; Feitosa, C.M.; de Freitas, R.M. Antioxidant activity of Citrus limon essential oil in mouse hippocampus. Pharm. Biol. 2011, 49, 709–715. [Google Scholar] [CrossRef]
- Spaggiari, L.; Squartini Ramos, G.B.; Squartini Ramos, C.A.; Ardizzoni, A.; Pedretti, N.; Blasi, E.; De Seta, F.; Pericolini, E. Anti-Candida and anti-inflammatory properties of a vaginal gel formulation: Novel data concerning vaginal infection and dysbiosis. Microorganisms 2023, 11, 1551. [Google Scholar] [CrossRef]
- Amorim, J.L.; Simas, D.L.R.; Pinheiro, M.M.G.; Moreno, D.S.A.; Alviano, C.S.; da Silva, A.J.R.; Dias Fernandes, P. Anti-inflammatory properties and chemical characterization of the essential oils of four citrus species. PLoS ONE 2016, 11, e0153643. [Google Scholar] [CrossRef]
- El Makawy, A.I.; Mabrouk, D.M.; Mohammed, S.E.; Abdel-Aziem, S.H.; El-Kader, H.A.A.; Sharaf, H.A.; Youssef, D.A.; Ibrahim, F.M. The suppressive role of nanoencapsulated chia oil against DMBA-induced breast cancer through oxidative stress repression and tumor genes expression modulation in rats. Mol. Biol. Rep. 2022, 49, 10217–10228. [Google Scholar] [CrossRef] [PubMed]
- Pharmacopoeia, E. General Organization for Governmental Printing Office; Ministry of Health: Cairo, Egypt, 1984; pp. 31–33. [Google Scholar]
- Kuroiwa, T.; Shino, H.; Yoshioka, T.; Doi, T.; Nishinomiya, T. Flavor encapsulation into chitosan-oleic acid complex particles and its controlled release characteristics during heating processes. LWT 2022, 167, 113815. [Google Scholar] [CrossRef]
- Zhang, X.-Z.; Tian, F.-J.; Hou, Y.-M.; Ou, Z.-H. Preparation and in vitro in vivo characterization of polyelectrolyte alginate–chitosan complex based microspheres loaded with verapamil hydrochloride for improved oral drug delivery. J. Incl. Phenom. Macrocycl. Chem. 2015, 81, 429–440. [Google Scholar] [CrossRef]
- Kamel, R.; Elmotasem, H.; Abdelsalam, E.; Salama, A. Lepidium sativum seed oil 3D nano-oleogel for the management of diabetic wounds: GC/MS analysis, in-vitro and in-vivo studies. J. Drug Deliv. Sci. Technol. 2021, 63, 102504. [Google Scholar] [CrossRef]
- Mostafa, D.M.; Abd El-Alim, S.H.; Asfour, M.H.; Al-Okbi, S.Y.; Mohamed, D.A.; Hamed, T.E.-S.; Awad, G. Transdermal fennel essential oil nanoemulsions with promising hepatic dysfunction healing effect: In vitro and in vivo study. Pharm. Dev. Technol. 2019, 24, 729–738. [Google Scholar] [CrossRef]
- Asfour, M.H.; Mohsen, A.M. Formulation and evaluation of pH-sensitive rutin nanospheres against colon carcinoma using HCT-116 cell line. J. Adv. Res. 2018, 9, 17–26. [Google Scholar] [CrossRef] [PubMed]
- Elhabak, M.; Ibrahim, S.; Abouelatta, S.M. Topical delivery of l-ascorbic acid spanlastics for stability enhancement and treatment of UVB induced damaged skin. Drug Deliv. 2021, 28, 445–453. [Google Scholar] [CrossRef]
- de Bastiani, F.W.M.d.S.; Spadari, C.d.C.; De Matos, J.K.R.; Salata, G.C.; Lopes, L.B.; Ishida, K. Nanocarriers provide sustained antifungal activity for amphotericin B and miltefosine in the topical treatment of murine vaginal candidiasis. Front. Microbiol. 2020, 10, 2976. [Google Scholar] [CrossRef] [PubMed]
- Yaralizadeh, M.; Abedi, P.; Najar, S.; Namjoyan, F.; Saki, A. Effect of Foeniculum vulgare (fennel) vaginal cream on vaginal atrophy in postmenopausal women: A double-blind randomized placebo-controlled trial. Maturitas 2016, 84, 75–80. [Google Scholar] [CrossRef]
- Abd El-Alim, S.H.; Salama, A.; Darwish, A.B. Provesicular elastic carriers of Simvastatin for enhanced wound healing activity: An in-vitro/in-vivo study. Int. J. Pharm. 2020, 585, 119470. [Google Scholar] [CrossRef]
- Zhang, X.; Liu, D.; Jin, T.Z.; Chen, W.; He, Q.; Zou, Z.; Zhao, H.; Ye, X.; Guo, M. Preparation and characterization of gellan gum-chitosan polyelectrolyte complex films with the incorporation of thyme essential oil nanoemulsion. Food Hydrocoll. 2021, 114, 106570. [Google Scholar] [CrossRef]
- Ammar, N.M.; Hassan, H.A.; Mohammed, M.A.; Serag, A.; Abd El-Alim, S.H.; Elmotasem, H.; El Raey, M.; El Gendy, A.N.; Sobeh, M.; Abdel-Hamid, A.-H.Z. Metabolomic profiling to reveal the therapeutic potency of Posidonia oceanica nanoparticles in diabetic rats. RSC Adv. 2021, 11, 8398–8410. [Google Scholar] [CrossRef] [PubMed]
- Mapoung, S.; Semmarath, W.; Arjsri, P.; Umsumarng, S.; Srisawad, K.; Thippraphan, P.; Yodkeeree, S.; Limtrakul, P. Determination of Phenolic Content, Antioxidant Activity, and Tyrosinase Inhibitory Effects of Functional Cosmetic Creams Available on the Thailand Market. Plants 2021, 10, 1383. [Google Scholar] [CrossRef] [PubMed]
- Vilas-Boas, A.A.; Campos, D.A.; Nunes, C.; Ribeiro, S.; Nunes, J.; Oliveira, A.; Pintado, M. Polyphenol extraction by different techniques for valorisation of non-compliant portuguese sweet cherries towards a novel antioxidant extract. Sustainability 2020, 12, 5556. [Google Scholar] [CrossRef]
- Murugesan, S.; Venkateswaran, M.R.; Jayabal, S.; Periyasamy, S. Evaluation of the antioxidant and anti-arthritic potential of Zingiber officinale Rosc. by in vitro and in silico analysis. S. Afr. J. Bot. 2020, 130, 45–53. [Google Scholar] [CrossRef]
- de Macêdo Andrade, A.C.; Rosalen, P.L.; Freires, I.A.; Scotti, L.; Scotti, M.T.; Aquino, S.G.; de Castro, R.D. Antifungal Activity, Mode of Action, Docking Prediction and Anti-biofilm Effects of (+)-β-pinene Enantiomers against Candida spp. Curr. Top. Med. Chem. 2018, 18, 2481–2490. [Google Scholar] [CrossRef] [PubMed]
- El-Fadaly, A.A.; Younis, I.Y.; Abdelhameed, M.F.; Ahmed, Y.H.; Ragab, T.I.M.; El Gendy, A.E.-N.G.; Farag, M.A.; Elshamy, A.I.; Elgamal, A.M. Protective Action Mechanisms of Launaea mucronata Extract and Its Nano-Formulation against Nephrotoxicity in Rats as Revealed via Biochemical, Histopathological, and UPLC-QTOF–MS/MS Analyses. Metabolites 2023, 13, 786. [Google Scholar] [CrossRef]
- OECD. OECD Guidelines for the Testing of Chemicals—Test No. 402: Acute Dermal Toxicity; OECD: Paris, France, 2017; Volume 402. [Google Scholar]
- De Bernardis, F.; Santoni, G.; Boccanera, M.; Spreghini, E.; Adriani, D.; Morelli, L.; Cassone, A. Local anticandidal immune responses in a rat model of vaginal infection by and protection against Candida albicans. Infect. Immun. 2000, 68, 3297–3304. [Google Scholar] [CrossRef]
- Radithia, D.; Tanjungsari, R.; Ernawati, D.S.; Parmadiati, A.E. The effectiveness of essential oil from Citrus limon peel on Candida albicans biofilm formation: An experimental in vivo study. J. Taibah Univ. Med. Sci. 2023, 18, 190–195. [Google Scholar] [CrossRef]
- Al-Mousawi, A.M.; Kulp, G.A.; Branski, L.K.; Kraft, R.; Mecott, G.A.; Williams, F.N.; Herndon, D.N.; Jeschke, M.G. Impact of anesthesia, analgesia, and euthanasia technique on the inflammatory cytokine profile in a rodent model of severe burn injury. Shock 2010, 34, 261–268. [Google Scholar] [CrossRef]
- Suvarna, K.S.; Layton, C.; Bancroft, J.D. Bancroft’s Theory and Practice of Histological Techniques; Elsevier Health Sciences: Amsterdam, The Netherlands, 2018. [Google Scholar]
- Abd-Elsalam, W.H.; Nagy, Y.I.; Abouelatta, S.M. Tailoring thixotropic mixed-lipid nanoconstructs of voriconazole for the management of Vulvovaginal candidiasis: Formulation, statistical optimization, in vitro characterization and in vivo assessment. Drug Deliv. 2021, 28, 1877–1889. [Google Scholar] [CrossRef] [PubMed]

| Formulation | CH (g/L) | OA:LPEO | LPEO Content ± SD (%) | Particle Size ± SD (nm) | Zeta Potential ± SD (mV) | PDI ± SD |
|---|---|---|---|---|---|---|
| F1 | 5 | 2:1 | 71.02 ± 0.11 | 234.14 ± 0.11 | 65.4 ± 2.9 | 0.436 ± 0.020 |
| F2 | 5 | 1:1 | 55.16 ± 0.18 | 345.40 ± 1.71 | 53.2 ± 0.8 | 0.498 ± 0.090 |
| F3 | 5 | 1:2 | 68.52 ± 0.29 | 517.30 ± 2.23 | 59.5 ± 3.7 | 0.694 ± 0.110 |
| F4 | 10 | 2:1 | 86.71 ± 0.97 | 442.54 ± 0.91 | 68.6 ± 4.4 | 0.248 ± 0.060 |
| F5 | 10 | 1:1 | 84.62 ± 1.25 | 750.20 ± 3.48 | 99.5 ± 1.5 | 0.317 ± 0.010 |
| F6 | 10 | 1:2 | 85.40 ± 2.74 | 757.70 ± 4.93 | 62.5 ± 1.9 | 0.773 ± 0.113 |
| Sample (Initial Concentration) | Staphylococcus aureus | Escherichia coli | Candida albicans | |||
|---|---|---|---|---|---|---|
| MIC (µg/mL) | MMC (µg/mL) | MIC (µg/mL) | MMC (µg/mL) | MIC (µg/mL) | MMC (µg/mL) | |
| LPEO (50 mg/mL) | 312.2 ± 2.57 | 625.00 ± 5.23 | 156.25 ± 3.12 | 312.50 ± 4.81 | 39.06 ± 0.79 | 78.13 ± 1.09 |
| LPEO-CH-OA-NPs (5 mg/mL) | 39.06 ± 1.53 | 156.25 ± 6.21 | 78.13 ± 1.27 | 78.13 ± 2.04 | 78.13 ± 1.34 | 156.25 ± 1.84 |
| LPEO-CH-OA-NPs (20 mg/mL) | 19.53 ± 1.50 | 19.53 ± 0.99 | 19.53 ± 1.78 | 39.06 ± 0.96 | 9.78 ± 0.91 | 19.53 ± 1.01 |
| LPEO-CH-OA-NPs (50 mg/mL) | 9.77 ± 1.05 | 19.53 ± 1.42 | 9.78 ± 0.94 | 19.53 ± 1.65 | 9.78 ± 0.86 | 9.78 ± 0.92 |
| ID | Proposed Name | Molecular Formula | Rt (min) | m/z Measured Mass [M + H]+ | MS2 Fragments (m/z, % Relative Abundance) | Error (mDa) |
|---|---|---|---|---|---|---|
| 1 | Citronellic Acid | C10H18O2 | 6.4 | 153.1273 | 43 (100.0); 55 (54.1); 67 (49.8); 107 (18.3); 93 (16.8); 81 (15.4) | 0.07 |
| 2 | Eriodictyol | C15H12O6 | 7.9 | 289.0728 | 135 (100); 107 (78.7); 93 (33.8); 43 (7.1); 69 (20.3) | 0.00 |
| 3 | Linalool Oxide | C10H18O2 | 10.5 | 153.1274 | 43 (100); 55 (65.1); 81 (33.6); 67 (35.3); 91 (26.1) | 0.04 |
| 4 | 1,8-Octanedioic Acid | C8H14O4 | 10.7 | 175.0816 | 133 (100); 89 (27.2); 177 (47.5); 45 (38.3) | 0.17 |
| 5 | 3-Hydroxycapric Acid | C10H20O3 | 10.8 | 189.1483 | 107 (100.0); 43 (35.4); 135 (58.1); 81 (27.1); 153 (11.6) | 0.23 |
| 6 | Terpinolene | C10H16 | 17.1 | 137.1325 | 55 (100.0); 41 (61.0); 67 (74.2); 81 (71.0); 95 (40.1); 53 (26.8); 56 (30.8) | 0.00 |
| 7 | Mentha-1(7),8-dien | C10H16 | 17.5 | 137.1325 | 55 (100.0); 41 (63.6); 81 (64.5); 67 (78.1); 53 (24.8); 56 (39.1); 95 (46.6) | −0.10 |
| 8 | Limonene | C10H16 | 19.0 | 137.1325 | 41 (36.2); 108 (100.0); 55 (33.6); 56 (68.1); 95 (10.3); 81 (20.2); 53 (15.0) | −0.20 |
| 9 | α-Terpinene | C10H16 | 19.2 | 137.1325 | 108 (100.0) 41 (96.3); 55 (87.8); 81 (96.9); 67 (82.2); 53 (48.5); 95 (43.8) | −0.30 |
| 10 | β-pinene | C10H16 | 19.5 | 137.1325 | 41 (100.0); 55 (90.1); 81 (91.3); 67 (52.4); 43 (52.2); 53 (35.6); 95 (38.1) | −0.20 |
| 11 | Myrcene | C10H16 | 19.7 | 137.1325 | 41 (67.7); 55 (66.7); 81 (55.7); 43 (25.9); 67 (38.4); 95 (9.2); 53 (21.3); 108 (100.0) | −0.30 |
| 12 | Camphene | C10H16 | 21.4 | 137.1325 | 121 (100.0); 55 (7.9); 43 (3.0); 136 (24.7); 53 (2.2); 120 (13.6); 41 (2.0) | 0.10 |
| Ligand (RMSD) | ||||||||
|---|---|---|---|---|---|---|---|---|
| 5TZ1 | 4QUV | 1EQC | 5UIV | |||||
| RMSD | 0.2 | 0.7 | 0.5 | 0.8 | ||||
| Compound | Binding Energy (kcal mol−1) | Interaction | Binding Energy (kcal mol−1) | Interaction | Binding Energy (kcal mol−1) | Interaction | Binding Energy (kcal mol−1) | Interaction |
| Miconazole Standard | −7.065 | * HIS A: 377, * PHE A: 233, * LEU A: 376, * TYR A: 118, * ILE A: 231, * VAL A: 234, ** SER A: 507, ** TYR A: 64 | −6.860 | * TRP A: 256, * PHE A: 312, * LEU A: 346, * ARG A: 395, * LYS A: 259, * LYS A: 319, ** ASP A: 399, ** HIS A: 357, ** ARG A: 398 | −6.979 | * PHE A: 258, * TRP A: 373, * TYR A: 255, * TYR A: 317, ** GLU A: 292, ** ARG A: 309, ** ASP A: 145, | −6.121 | * TYR A: 161, * TYR A: 100, ** ARG A: 39, ** LYS A: 17, ** GLU A: 159, ** ASP A: 13 |
| Terpinolene | −4.760 | ND | −4.880 | ND | −4.645 | ND | −5.099 | * PHE A: 67, * LEU A: 51, * TYR A: 161, * PRO A: 37, * TYR A: 100 |
| Mentha-1(7),8-dien | −4.620 | ND | −4.780 | ND | −4.459 | ND | −5.148 | * PHE A: 67, * LEU A: 51, * TYR A: 161, * PRO A: 37, * TYR A: 100 |
| Limonene | −4.610 | ND | −5.110 | * HIS A: 357, * TRP A: 411, * TRP A: 352, * LYS A: 319, * LEU A: 347, * LEU A: 346, * ARG A: 323, * CYS A: 403 | −4.672 | ND | −5.520 | * PHE A: 67, * LEU A: 51, * TYR A: 161, * PRO A: 37, * TYR A: 100 |
| α-Terpinene | −4.560 | ND | −5.240 | * LYS A: 319, * LEU A: 346, * TRP A: 352, * HIS A: 357, * CYS A: 403 | −4.538 | ND | −5.609 | * PHE A: 67, * LEU A: 51, * TYR A: 161, * PRO A: 37, * TYR A: 100 |
| β-pinene | −4.700 | ND | −4.180 | ND | −4.917 | * PHE A: 144, * PHE A: 258, * TYR A: 29, * LEU A: 304, * HIS A: 135, * TRP A: 363 | −3.970 | ND |
| Myrcene | −5.040 | * LEU A: 121, * TYR A: 118, * LEU A: 376, * PHE A: 380, * HIS A: 377 | −5.490 | * HIS A: 357, * TRP A: 411, * TRP A: 352, * LYS A: 319, * LEU A: 347, * LEU A: 346, * PHE A: 322, * ARG A: 323 | −4.808 | * PHE A: 144, * PHE A: 258, * TYR A: 29, * LEU A: 304, * HIS A: 135, * TRP A: 363 | −6.180 | * PHE A: 67, * LEU A: 51, * TYR A: 161, * PRO A: 37, * TYR A: 100 |
| Camphene | −4.530 | ND | −4.150 | ND | −4.814 | * PHE A: 258, * TYR A: 255, * TRP A: 373, * TYR A: 29, * TRP A: 363, * PHE A: 144 | −3.940 | ND |
| Citronellic Acid | −5.510 | * LEU A: 376, * CYS A: 470, * PRO A: 375, * MET A: 374, ** ARG A: 381, ** TYR A: 132 | −5.144 | * TRP A: 352, * LEU A: 346, * ARG A: 323, * TYR A: 414, * LYS A 319, ** LYS A: 319 | −5.596 | * PHE A: 144, * PHE A: 258, * TYR A: 29, * TYR A: 255, ** HIS A: 135, ** ASN A: 191, ** GLU A: 292 | −6.160 | * PRO A: 37, * TYR A: 161, * TYR A: 100, * PHE A: 67, ** ARG A: 92 |
| Hydroxycapric Acid | −6.030 | * LEU A: 376, * TYR A: 118, ** GLY A: 464, ** ARG A: 381, ** TYR A: 132, ** TYR A: 118 | −5.355 | ** LYS A: 259, ** ARG A: 398, ** THR A: 255, ** TRP A: 256 | −6.210 | * PHE A: 144, * PHE A: 258, ** GLU A: 27, ** GLU A: 292, ** ASN A: 191, ** HIS A: 135 | −6.320 | * PRO A: 37, * PHE A: 67, * TYR A: 161, * TYR A: 100, ** ARG A: 92, ** GLN A: 167 |
| Eriodictyol | −6.090 | * GLY A: 307, * ILE A: 304, * CYS A: 470, * PRO A: 375, ** PRO A: 462, ** PRO A: 375 | −6.130 | * ASP A: 399, ** LYS A: 259, ** ARG A: 395, ** ARG A: 398 | −7.077 | * PHE A: 144, * TRP A: 363, * GLU A: 27, ** ARG A: 309, ** GLY A: 306, ** GLU A: 292, ** ASN A: 191 | −5.947 | * PHE A: 67, * PRO A: 37, * TYR A: 100, ** ARG A: 71, ** ARG A: 92, ** TYR A: 161, ** GLU A: 159 |
| Linalool Oxide | −5.180 | * TYR A: 118, * LEU A: 376, * HIS A: 377, ** MET A: 508 | −4.520 | ND | −5.704 | * PHE A: 144, * PHE A: 258, * TYR A: 29, * HIS A: 135, * TRP A: 363, ** GLU A: 292, ** ASN A: 146 | −5.250 | * PHE A: 67, * LEU A: 51, * TYR A: 161, * PRO A: 37, * TYR A: 100 |
| 1,8-Octanedioic Acid | −5.450 | * LEU A: 376, * CYS A: 470, ** TYR A: 118, ** TYR A: 132, ** ARG A: 381, ** PRO A: 375 | −4.770 | ND | −5.661 | * PHE A: 144, ** GLU A: 27, ** HIS A: 135, ** ASN A: 191, ** LEU A: 304 | −6.101 | * PRO A: 37, * TYR A: 100, ** ARG A: 71, ** GLN A: 167 |
| Lesion Type | Negative Control | Positive Control | Topical Cream Control | Standard Drug (Miconazole) | LPEO 5% | LPEO 10% | LPEO Cream 5% | LPEO Cream 10% |
|---|---|---|---|---|---|---|---|---|
| Mucosa Necrosis | − | ++ | − | − | − | − | − | − |
| Hyperplastic Mucosa | − | +++ | + | ++ | ++ | + | + | − |
| Inflammatory Cells Infiltration | − | +++ | ++ | + | ++ | + | + | − |
| Submucosal Edema | − | ++ | ++ | + | + | + | + | + |
| Congested Blood Vessels | − | +++ | − | − | − | − | − | − |
| Formulation | CH (g/L) | OA:LPEO |
|---|---|---|
| F1 | 5 | 2:1 |
| F2 | 5 | 1:1 |
| F3 | 5 | 1:2 |
| F4 | 10 | 2:1 |
| F5 | 10 | 1:1 |
| F6 | 10 | 1:2 |
Disclaimer/Publisher’s Note: The statements, opinions and data contained in all publications are solely those of the individual author(s) and contributor(s) and not of MDPI and/or the editor(s). MDPI and/or the editor(s) disclaim responsibility for any injury to people or property resulting from any ideas, methods, instructions or products referred to in the content. |
© 2024 by the authors. Licensee MDPI, Basel, Switzerland. This article is an open access article distributed under the terms and conditions of the Creative Commons Attribution (CC BY) license (https://creativecommons.org/licenses/by/4.0/).
Share and Cite
Ibrahim, F.M.; Shalaby, E.S.; Abdelhameed, M.F.; El-Akad, R.H.; Ahmed, K.A.; Abdel-Aziz, M.S.; El Habbasha, E.S.; Rodrigues, C.V.; Pintado, M. Bioactive Potential of Chitosan–Oleic Acid Nanoparticles Loaded with Lemon Peel Essential Oil for Topical Treatment of Vulvovaginal Candidiasis. Molecules 2024, 29, 5766. https://doi.org/10.3390/molecules29235766
Ibrahim FM, Shalaby ES, Abdelhameed MF, El-Akad RH, Ahmed KA, Abdel-Aziz MS, El Habbasha ES, Rodrigues CV, Pintado M. Bioactive Potential of Chitosan–Oleic Acid Nanoparticles Loaded with Lemon Peel Essential Oil for Topical Treatment of Vulvovaginal Candidiasis. Molecules. 2024; 29(23):5766. https://doi.org/10.3390/molecules29235766
Chicago/Turabian StyleIbrahim, Faten M., Eman Samy Shalaby, Mohamed F. Abdelhameed, Radwa H. El-Akad, Kawkab A. Ahmed, Mohamed S. Abdel-Aziz, El Sayed El Habbasha, Cristina V. Rodrigues, and Manuela Pintado. 2024. "Bioactive Potential of Chitosan–Oleic Acid Nanoparticles Loaded with Lemon Peel Essential Oil for Topical Treatment of Vulvovaginal Candidiasis" Molecules 29, no. 23: 5766. https://doi.org/10.3390/molecules29235766
APA StyleIbrahim, F. M., Shalaby, E. S., Abdelhameed, M. F., El-Akad, R. H., Ahmed, K. A., Abdel-Aziz, M. S., El Habbasha, E. S., Rodrigues, C. V., & Pintado, M. (2024). Bioactive Potential of Chitosan–Oleic Acid Nanoparticles Loaded with Lemon Peel Essential Oil for Topical Treatment of Vulvovaginal Candidiasis. Molecules, 29(23), 5766. https://doi.org/10.3390/molecules29235766

